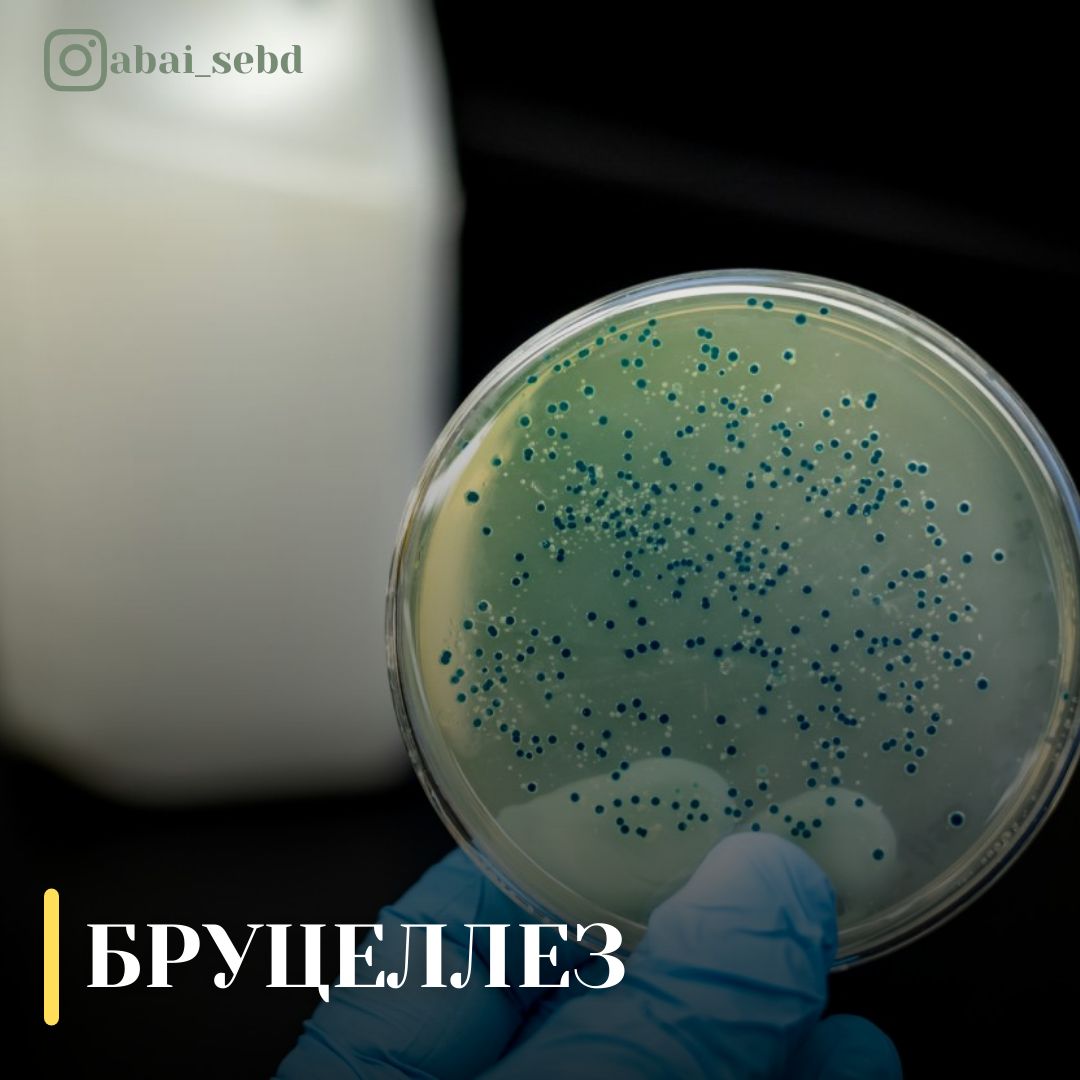
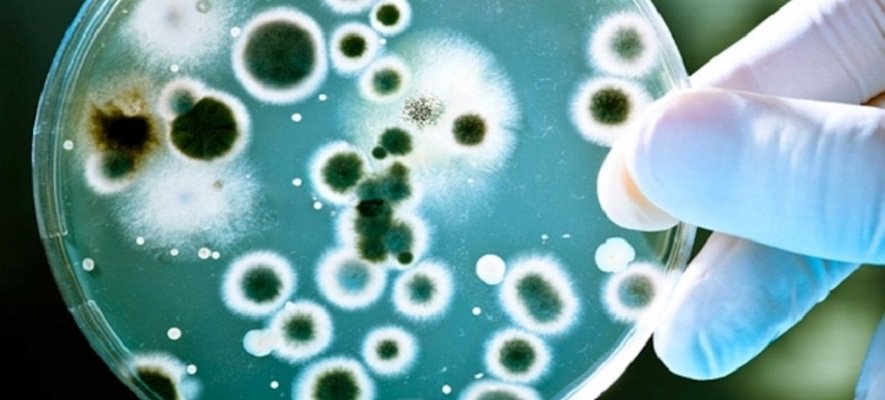
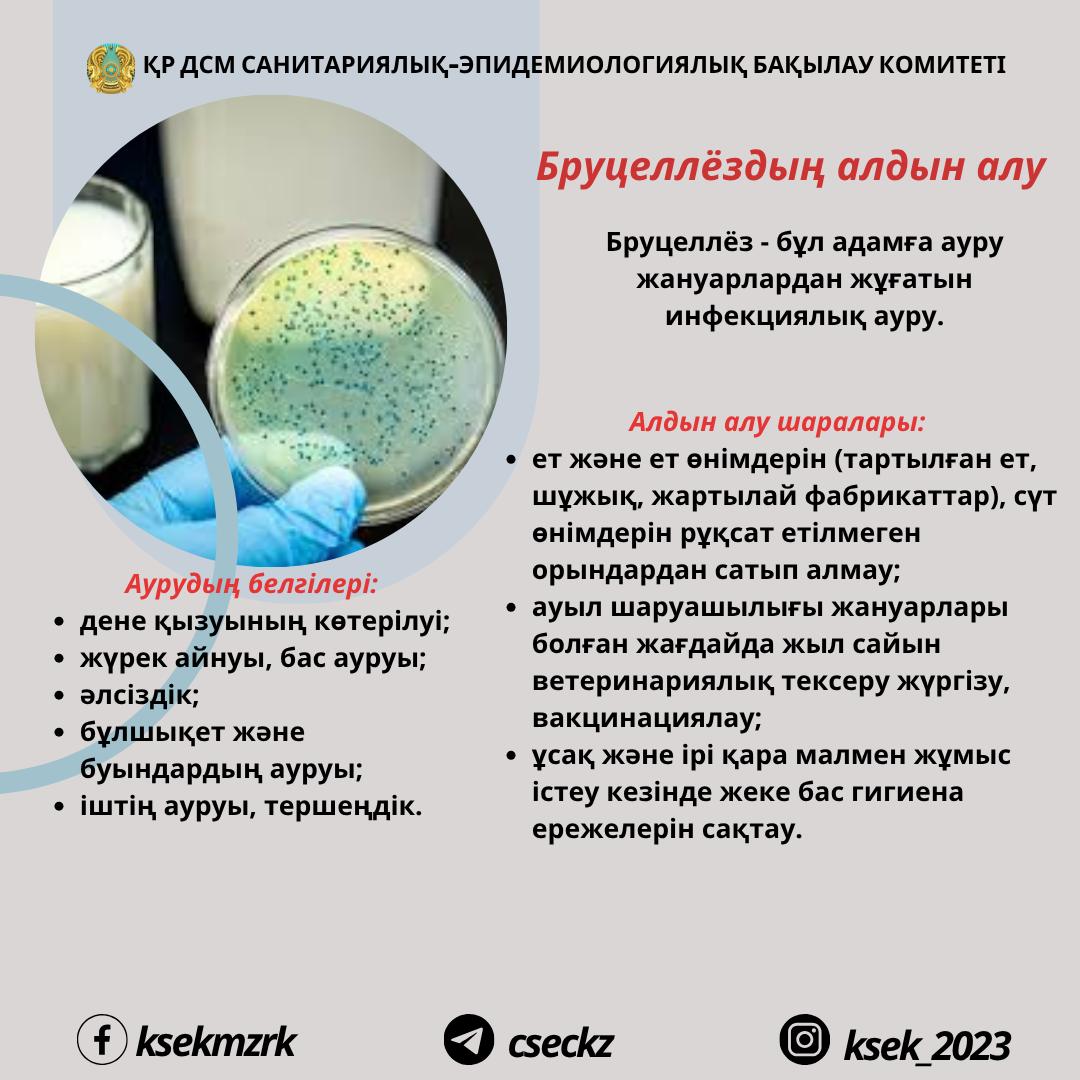

Вирус бруцеллеза
Вирус бруцеллеза 112 фотографий
Рисовать простые пейзажи
Суть битвы за москву 1941
Архангельск девочка родила в тц
Со скольки лет можно на концерт майота
Ручные заклепочники 4 мм
Вкусный торт быстро и недорого
Обратная засыпка котлована расценка
Моды бмд
Инстаграм виндовс 7
Наборы красок для картины по номерам
Театр моссовета марчелли
Какой секрет а 4
Тайна блум
На каких градусах стирать куртку
Кишечная группа инфекций анализ
Какой творог покупать в магазине
Красивая обложка блокнота
Городской санитарно эпидемиологический контроль
Joy challenges
Доминиканская республика из москвы